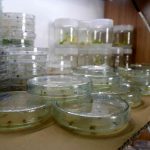
blank

Türk Bilim İnsanları Kuraklığa Çare Bulmak İçin Kolları Sıvadı!

Son zamanlarda kuralığın hem ülkemizi hem de dünyayı tehlikeye soktuğu biliniyor. Bu kapsamda Sivas’ta Türk bilim insanları kuraklığa çare bulmak için kolları sıvadı!
Tüm dünyada endişeyle karşılanan kuraklık tehdidine karşı Sivas Bilim ve Teknoloji Üniversitesi Tarım Bilimleri ve Teknoloji Fakültesi’nde kuraklıkla mücadele konusunda etkili bir çalışmanın yapıldığı belirlendi. Konuya dair açıklama yapan Sivas Bilim ve Teknoloji Üniversitesi Tarım Bilimleri ve Teknoloji Fakültesi Dekanı Prof. Dr. Tolga Karaköy; kendisi ve ekibinin kuraklığa karşı dayanıklı olan tohumları geliştirmek konusunda aralıksız bir şekilde çalıştıklarını ifade etti.
Kuraklık nedeniyle tarımsal üretimde azalma yaşanırken, bu sorunun üstesinden gelmek isteyen Türk bilim insanları çalışmalarına hız verdi. Rekolte ve verim kayıplarının yaşanılmaması için araştırmalarına yoğunluk verdiklerini ifade eden Prof. Dr. Tolga Karaköy; kuraklığın tehlikesine de değindi. Özellikle gelecekte gıda temini noktasında sorunlar yaşanılabileceğini ifade eden Karaköy; bundan dolayı ıslah ve üretin çalışmalarının planlı bir şekilde yapılmasının da şart olduğunu ifade etti.
Gıda Temininde Ciddi Sıkıntılar Yaşanabilir!
Sivas Bilim ve Teknoloji Üniversitesi Tarım Bilimleri ve Teknoloji Fakültesi Dekanı Prof. Dr. Tolga Karaköy yapmış olduğu açıklamada gelecekte gıda temini konusunda ciddi sorunların yaşanılmasının kuvvetle muhtemel olduğunun altını çizdi. Üretim planlamasının acilen yapılmasının önemine değinen Karaköy; bu kapsamda ekibinin de etkili bir çalışmanın içerisinde yer aldıklarını ifade etti. Öte yandan ıslah çalışmalarının da sürdüğünü açıklayan Prof. Dr. Tolga Karaköy; özellikle buğday ve tahıllar üzerine ıslah çalışmalarını rutin olarak sürdürdüklerini belirtti.